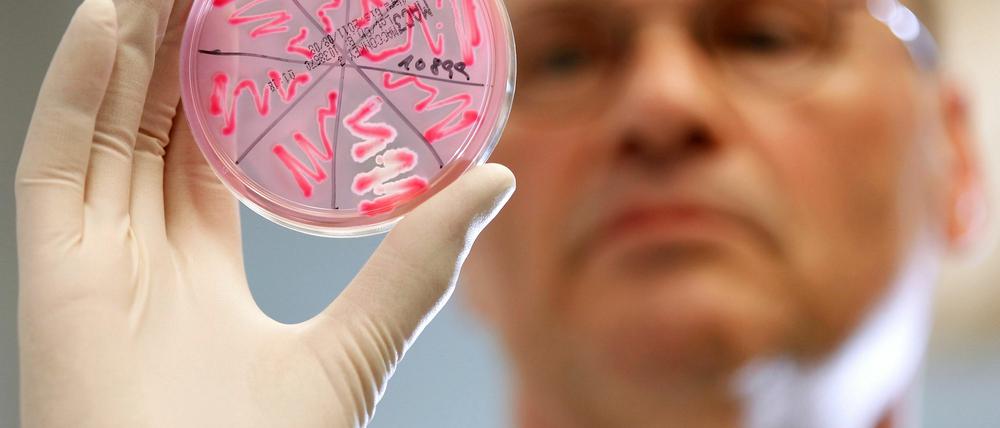

© dapd
Nordrhein-Westfalen: Schule wegen Ehec-Infektionen geschlossen
Nach mehreren Erkrankungen mit dem gefährlichen Darmkeim Ehec ist eine Schule in Altenbeken (Kreis Paderborn) für über eine Woche gesperrt worden. Mit der Schließung bis zum Dienstag nächster Woche soll die Inkubationszeit abgewartet werden.
Stand:
Bis zum 5. Juli soll der Schulbetrieb ruhen, wie die Kreisbehörde am Montag mitteilte. Damit werde die Zeit zwischen einer möglichen Infektion und dem Ausbruch der Krankheit abgewartet. "Die Schulschließung ist eine rein vorsorgliche Maßnahme", sagte Landrat Manfred Müller. Die Entscheidung sei mit dem Robert-Koch-Institut abgesprochen.
In den vergangenen Wochen hatte sich drei Schüler mit den Ehec-Bakterien angesteckt. Zudem litten sie an dem gefährlichen Hämolytisch-Urämischen Syndrom (HUS). Wie die Behörde nun mitteilt, haben sich möglicherweise auch drei Mitarbeiterinnen der Essensausgabe an der Schule sowie ein Koch des Caterers mit den Ehec-Bakterien infiziert. "Es könnte durchaus sein, dass sich die Kinder über kontaminierte Lebensmittel angesteckt haben", sagte der Leiter des Kreisgesundheitsamtes, Georg Alles. Auch eine Schmierinfektion auf der Schultoilette wird nicht ausgeschlossen. Den drei Jungen geht es nach Angaben des Kreises inzwischen besser.
Die Schulküche wurde bis auf weiteres geschlossen. Sämtliche betroffenen Bereiche der Schule sollen nun gründlich gereinigt und desinfiziert werden. 30 Kinder, die in der Schulküche gegessen haben, müssen sich auf Ehec testen lassen. (dapd/dpa)
- showPaywall:
- false
- isSubscriber:
- false
- isPaid: